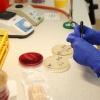

Fotoreportáž
Sestra je členem zdravotnického týmu II.
Autor: sol. | Datum: 06.04.2019
<< Zpět na seznam fotoreportáží
FOTOREPORTÁŽ: Náročná a nezastupitelná práce sester v Nemocnici Šumperk si zaslouží náš respekt. Nenahlíží na pacienta jako na diagnózu, ale snaží se mu naplnit potřeby, které vyvstávají spolu s jeho nemocí.
Aktuální fotogalerie

Zpěvačka Dasha za doprovodu Pajky Pajk Quintetu
FOTOREPORTÁŽ: Návštěvníci šumperského kulturáku zažili ve čtvrtek...

Zabíjačkové hody pokračují navíc s hudebním doprovodem
FOTOREPORTÁŽ: Ve Velkých Losinách vrcholí tradiční zabíjačka. V sobotu s...

Zabijačkové hody ve Velkých Losinách
FOTOREPORTÁŽ: Tradiční zabíjačkové speciality se konají o víkendu 12. a 13....

Křest nového románu Ivana Fíly Tisíc očí
FOTOREPORTÁŽ: Uskutečnil se v sobotu 6. prosince od třinácti hodin ve Velkolosinské...

Slavnostní ocenění dárců krve a krevní plazmy na Bruntálsku
FOTOREPORTÁŽ: Předávání medailí 27. listopadu.

Slavnostní ocenění dárců krve a krevní plazmy na Šumpersku
FOTOREPORTÁŽ: Předávání medailí 6. listopadu.

Přírodě blízká protipovodňová opatření na Šumpersku - říjen
FOTOREPORTÁŽ: Pokračují práce na řece Desné v úseku ř. km 12,088 – 14,231
Podmínky užití |
Prohlášení o přístupnosti |
Reklama |
Kontakty |
Nastavení souborů Cookies
Jakékoliv užití obsahu včetně převzetí, šíření či dalšího zpřístupňování článků a fotografií je bez souhlasu Sumpersko.net s.r.o. zakázáno.

Facebook